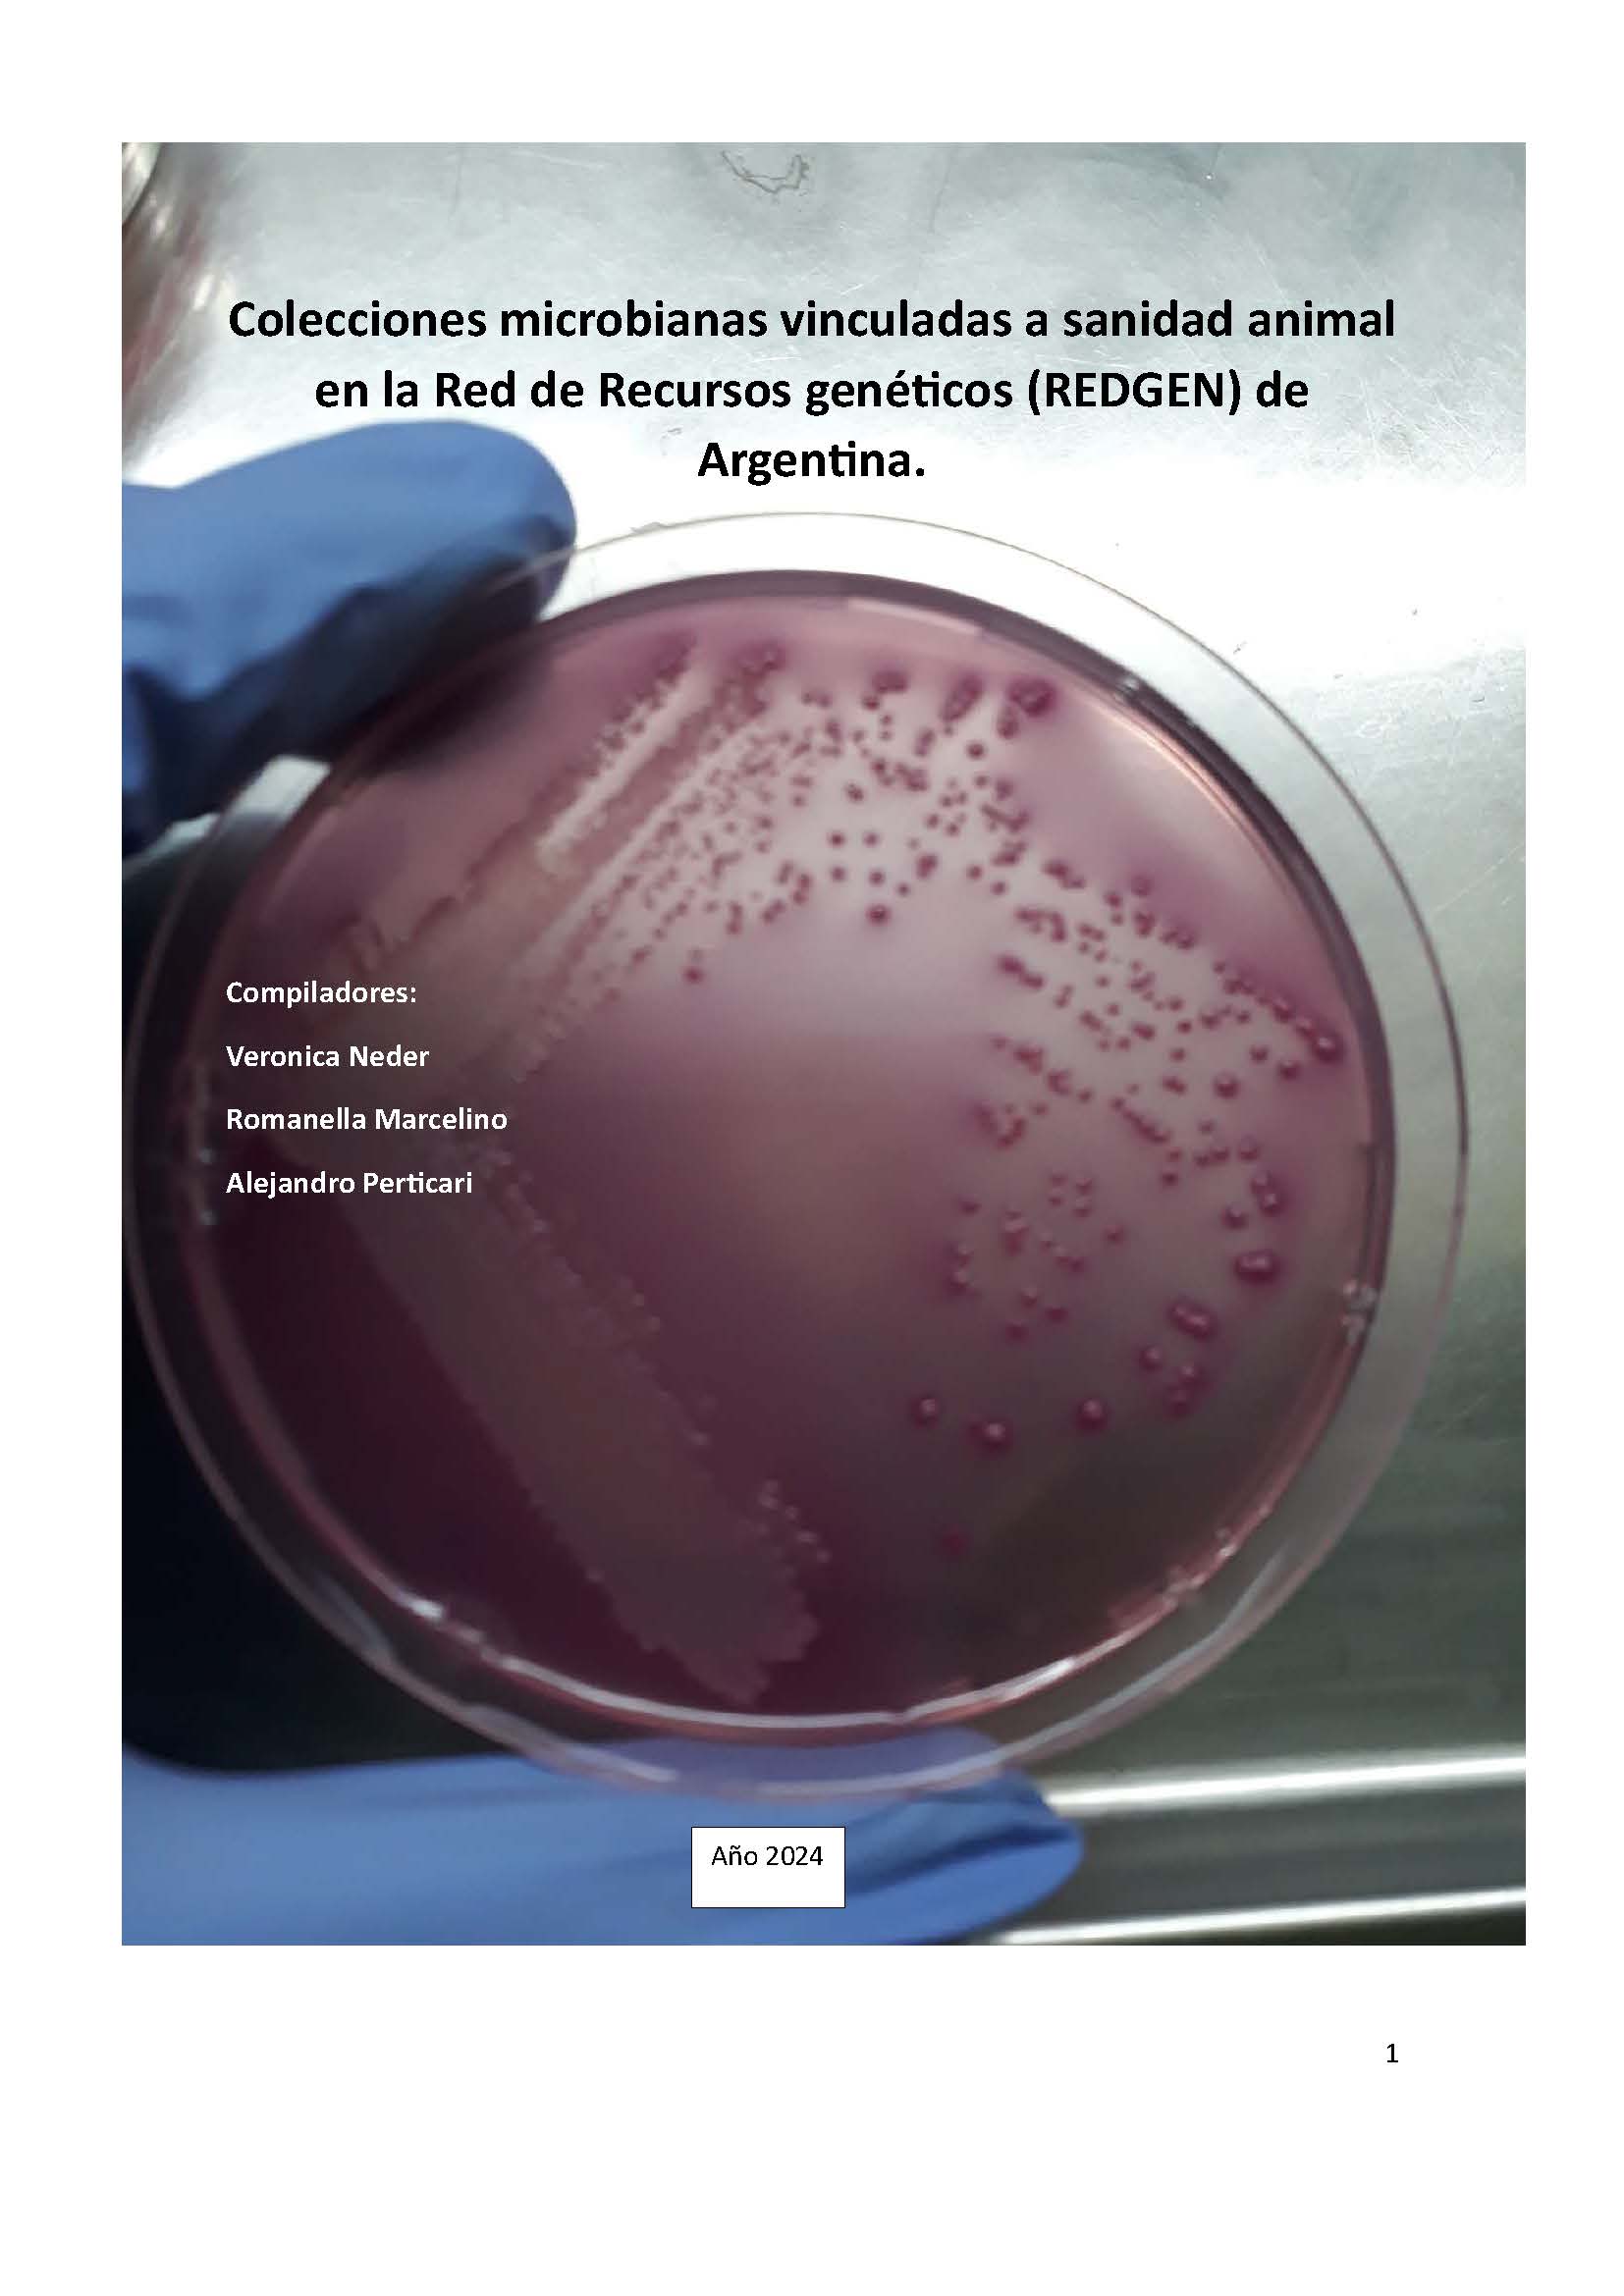
Thumbnail

Ver ítem
- xmlui.general.dspace_homeCentros Regionales y EEAsCentro Regional Santa FeEEA RafaelaInformes técnicosxmlui.ArtifactBrowser.ItemViewer.trail
Colecciones microbianas vinculadas a sanidad animal en la Red de Recursos genéticos (REDGEN) de Argentina.
Resumen
La Red de Recursos Genéticos (REDGEN) fue creada a fines de 2014 por decisión institucional con
la finalidad de converger en un solo ámbito todas las capacidades de conservación de los recursos
genéticos (RR. GG.) del INTA, para normalizar protocolos, evitando la pérdida de materiales y
adecuar lo conservado a la normativa vigente. Como así también colaborar desde el INTA en un
marco que conduzca a un Sistema Nacional de Preservación de Recursos
[ver mas...]
La Red de Recursos Genéticos (REDGEN) fue creada a fines de 2014 por decisión institucional con
la finalidad de converger en un solo ámbito todas las capacidades de conservación de los recursos
genéticos (RR. GG.) del INTA, para normalizar protocolos, evitando la pérdida de materiales y
adecuar lo conservado a la normativa vigente. Como así también colaborar desde el INTA en un
marco que conduzca a un Sistema Nacional de Preservación de Recursos Genéticos. Si bien en el
instituto se dispone de un alto porcentaje de los recursos genéticos vinculados a la Alimentación y
la Agricultura, hay otras instituciones nacionales que los preservan. Además, otra actividad
vinculada a la REDGEN es participar como referentes o colaborar, según el caso y pertinencia, en
los foros nacionales e internacionales donde este tema sea relevante dada la adhesión de
Argentina al Convenio de la Diversidad Biológica (CBD), al Tratado Internacional sobre los Recursos
Fitogenéticos para la Alimentación y la Agricultura (TIRFAA) y al Protocolo de Nagoya. En esa
decisión de 2014 se creó una red general de RR. GG. con tres subredes: Fitogenéticos,
Zoogenéticos y Microbianos con sus respectivos coordinadores. En 2018, culminan los proyectos y
programas nacionales y a fines de 2019 se crea el Programa Nacional de Recursos Genéticos y
Mejoramiento, y dentro de él una red con un solo coordinador que engloba cuatro subredes:
Fitogenéticos, Zoogenéticos, Microbianos y Forestales. Dentro de lo específico de la Red de
Recursos Genéticos Microbianos, por cuestiones de afinidad, se lo separó en tres grupos temáticos
de referencia Sanidad Vegetal, Agroindustria y Sanidad Animal. En el último, se encuadran más del
50 % de los RR. GG. Microbianos conservados en el INTA. El objetivo del presente trabajo es
mostrar las colecciones de cultivos microbianos presentes en sanidad animal.
[Cerrar]
Editor - Compilador
Descripción
Red de Recursos Genéticos (REDGEN) de Argentina.
Fecha
2024
Formato
pdf
Tipo de documento
documento de trabajo
Palabras Claves
Derechos de acceso
Abierto
Excepto donde se diga explicitamente, este item se publica bajo la siguiente descripción: Creative Commons Attribution-NonCommercial-ShareAlike 2.5 Unported (CC BY-NC-SA 2.5)


